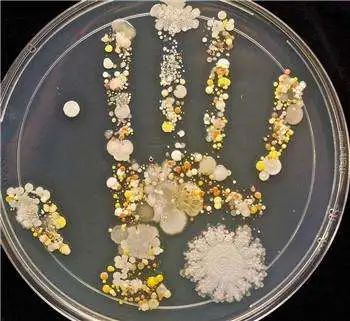

在外就餐,
我們總喜歡拿水燙一燙餐具,
雖然用處不大,
但是能給自己求個(gè)心理安慰。
但是在家,我們通常就是拿水沖一沖,
在自己的心里自己家的永遠(yuǎn)是最干凈的。
但實(shí)際上怎么樣呢?
那些肉眼看不到的細(xì)菌
真的不存在你家的餐具上么?
你家的餐具真的洗干凈了嗎?

先來看看我們家里常用的幾個(gè)清潔方法:
洗潔精清洗·手洗

洗潔精清洗+流水沖洗,一般清洗方法,也是傳統(tǒng)的基礎(chǔ)的清洗方法。但事實(shí)上,大多數(shù)洗潔精的成分是軟化水、表面活性劑、香糖,香精,并沒有殺菌滅菌的功能,其主要的功能還是在于清潔油污,只能洗的外表看起來干凈,但是還是會(huì)有細(xì)菌殘留。
洗碗機(jī)清洗·機(jī)洗

洗碗機(jī)清洗,帶有殺菌性質(zhì)的洗碗機(jī)成本投入高,一般普通家庭也舍不得買,便宜的也沒有殺菌滅菌的功能,只圖個(gè)省事,而且設(shè)備型號(hào)不同,洗滌餐具的數(shù)量也不同。再者洗碗機(jī)用來洗碗筷還行,那杯子呢?茶具呢?特別是玻璃的,容易碰壞不說,杯子口窄,能不能全面洗干凈都是一回事。
一般清洗后再用開水煮燙
有消毒概念的家庭,可能會(huì)選擇每次清洗完餐具,再用開水煮燙,但是要注意的是,至少要在溫度100℃左右的開水中持續(xù)浸泡5分鐘以上才能達(dá)到殺菌效果。還要等燙好了,再擦干放進(jìn)櫥柜,時(shí)間精力要花大把,可能在擦拭的過程中還會(huì)受二次污染。
還有更好的方法嗎?
如今氣溫還是居高不下,
細(xì)菌繁殖的非??焖伲?br/>有效的殺菌、滅菌是一個(gè)迫切的需求。
況且疫情還沒有結(jié)束,
時(shí)刻預(yù)防還是要銘記心中,
不能放松警惕。
這也是,
蘇州信圖納米科技有限公司
創(chuàng)立玻玻樂BBL品牌的初衷——
殺菌、滅菌,為健康生活貢獻(xiàn)一份力。
器具自帶抗菌殺菌的功能,
可以說是健康生活的又一大保障。
玻玻樂產(chǎn)品抗菌機(jī)制?
玻玻樂采用銀離子抗菌技術(shù),氧化銀在水中會(huì)水解成銀離子與氫氧根離子,其中溶出的銀離子便是造成抗菌效果的根源。2004年Sondi等人曾使用自行合成的納米銀粒子做為抗菌劑,測試它對大腸桿菌的抗菌效果。研究結(jié)果顯示與納米銀接觸的大腸桿菌,細(xì)胞壁上產(chǎn)生了許多小孔洞,納米銀粒子則積累在細(xì)胞壁上。細(xì)胞壁形成孔洞之后會(huì)使得細(xì)胞壁的透過度顯著增加,最后造成細(xì)胞的死亡。
但納米銀因?yàn)轭w粒小,安定性不佳,彼此間容易聚集成大顆粒,而降低抗菌效果。因此如何把納米銀均勻地分散在材料中,是制作納米銀產(chǎn)品的最大課題。
蘇州信圖納米科技有限公司經(jīng)過多年潛心研發(fā),拿到了食品級抗菌玻璃的研發(fā)專利,并將納米銀抗菌技術(shù)運(yùn)用至實(shí)際產(chǎn)品中。銀離子可以吸附細(xì)菌,細(xì)菌被銀離子吸附后,起呼吸作用的酶就失去功效,細(xì)菌的繁殖就會(huì)受到抑制,并會(huì)迅速死亡。銀離子針對常見的格蘭氏陽性和陰性細(xì)菌均有非常強(qiáng)的抑制和殺滅作用。

國家規(guī)定抗菌率大于90%的屬于抗菌產(chǎn)品
在外就餐講究衛(wèi)生安全,
在家更要重視健康生活,
畢竟“病從口入”,
注重吃喝的相關(guān)方面健康尤為地重要。
跟隨BBL一起暢想無菌生活~